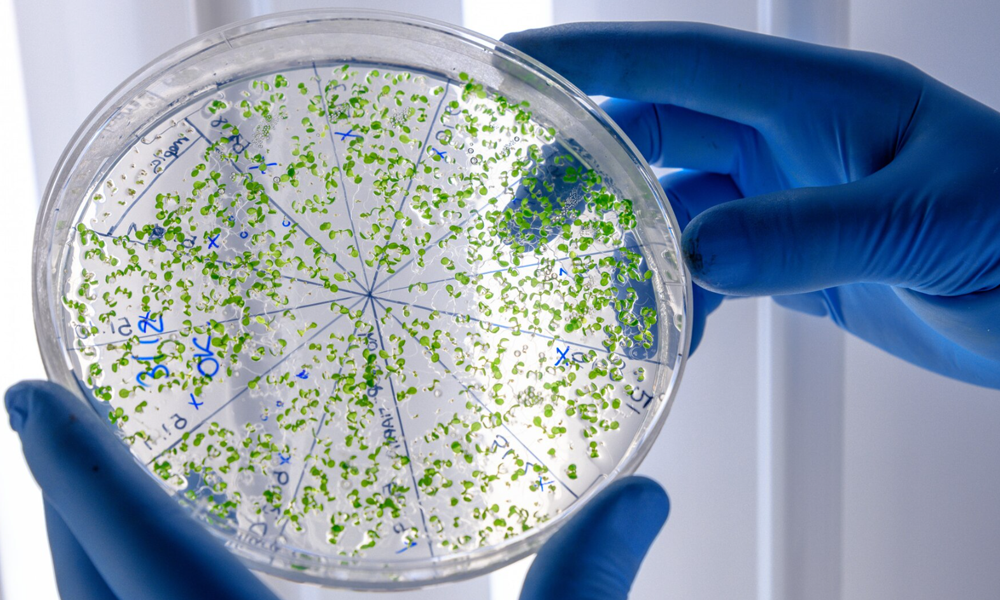

Adana Güzelyalı Hastanesi Mikrobiyoloji bölümü, enfeksiyon hastalıklarının tanı, tedavi ve takibinde kritik bir rol oynar. Mikrobiyoloji, vücutta bulunan veya vücuda giren mikroorganizmaların (bakteri, virüs, mantar ve parazitler gibi) araştırılması ve bu organizmaların hastalık yapıcı etkilerinin incelenmesidir. Hastanemizin mikrobiyoloji laboratuvarı, hasta sağlığını korumak için hızlı, güvenilir ve doğru testler sunarak, doğru tedaviye yönlendirme konusunda önemli bir görev üstlenmektedir.
Mikrobiyoloji Nedir?
Mikrobiyoloji, mikroorganizmaları (bakteri, virüs, mantar ve parazitler) inceleyen bir bilim dalıdır. Bu mikroorganizmalar, insanlar için hastalık yapabilirler. Mikrobiyoloji laboratuvarları, enfeksiyonların doğru bir şekilde teşhis edilmesine yardımcı olur ve doğru tedavi yöntemlerinin uygulanmasını sağlar. Adana Güzelyalı Hastanesi, enfeksiyonların önlenmesi ve tedavisi konusunda gelişmiş mikrobiyoloji testleri sunarak hasta bakımını en üst seviyeye taşımaktadır.
Adana Güzelyalı Hastanesi Mikrobiyoloji Hizmetleri
-
Enfeksiyon Tanı ve Tespiti
- Bakteriyolojik Testler: Bakteriyel enfeksiyonlar için yapılan kültür testleri, hangi bakterinin enfeksiyona neden olduğunu belirler ve doğru antibiyotik tedavisi için yardımcı olur.
- Virüs Testleri: Özellikle solunum yolu, sindirim sistemi ve cilt enfeksiyonları gibi virüs kaynaklı hastalıkların teşhisinde kullanılan PCR ve ELISA gibi testler.
- Mantar Enfeksiyonları: Cilt, tırnak, mukozalar ve iç organlarda oluşan mantar enfeksiyonları için kültür, mikroskopik inceleme ve testler.
- Parazit Tespiti: Bağırsak parazitleri, kan parazitleri gibi mikroorganizmaların varlığı için yapılan testler.
-
Mikrobiyolojik Testler ve Yöntemler
- Kültür Testleri: Enfeksiyon kaynağını tespit etmek için yapılan bakteriyolojik kültürler, doğru tedavi yöntemlerinin belirlenmesinde kritik öneme sahiptir.
- Antibiyogram Testi: Bakteriyel enfeksiyonların tedavisinde hangi antibiyotiğin daha etkili olduğunu belirlemek amacıyla yapılan test.
- Polimeraz Zincir Reaksiyonu (PCR) Testi: Virüs ve bakteriyel hastalıkların genetik materyalini tespit etmek için kullanılan ileri teknoloji bir testtir.
- Serolojik Testler: Vücutta belirli enfeksiyonlara karşı gelişen antikorların tespitiyle yapılan testler.
- Mikroskobik İnceleme: Hücresel düzeyde yapılan mikroskopik incelemeler ile mikroorganizmaların belirlenmesi ve enfeksiyon kaynağının anlaşılması.
-
Enfeksiyon Risk Değerlendirmesi
- Nosokomiyal Enfeksiyonlar (Hastane İçi Enfeksiyonlar): Hastane ortamında gelişebilecek enfeksiyonlar için düzenli izlemeler yapılır. Bu enfeksiyonlar, hastaların sağlık durumunu daha da kötüleştirebilir, bu nedenle enfeksiyon kontrolü önemlidir.
- Antibiyotik Direnci: Antibiyotiklere karşı dirençli bakterilerin varlığı, tedavi sürecinin başarısını etkileyebilir. Mikrobiyoloji bölümümüz, antibiyotik direnci konusunda da önemli analizler yaparak, doğru tedaviye yönlendirme sağlar.
-
Biyolojik Numune Analizleri
- Kan, İdrar, Süt, Balgam ve Diğer Numuneler: Mikrobiyoloji laboratuvarımız, çeşitli biyolojik numunelerden mikroorganizmaların tespiti için laboratuvar testleri yapmaktadır.
- Hastalıkların Erken Teşhisi: Bu testler, enfeksiyonların erken evrede tanınmasına yardımcı olur ve hastalıkların yayılmasını önlemeye yönelik tedavi uygulanmasını sağlar.
-
Viral Enfeksiyonlar ve Takip
- Hepatit Testleri: Hepatit A, B, C virüsleri için yapılan testler, enfeksiyonun erken teşhis edilmesini sağlar.
- HIV ve Diğer Retrovirüsler: HIV virüsünün tespiti ve diğer retrovirüslerin araştırılması.
- Influenza ve Diğer Solunum Yolu Virüsleri: Grip, RSV gibi solunum yolu enfeksiyonlarına yönelik testler.
-
Aşı ve İmmünolojik Testler
- Aşı Takibi: Aşılanma durumu ve immün yanıtlar, hastaların bağışıklık durumunu belirlemek için mikrobiyoloji laboratuvarında test edilir.
- İmmünoloji Testleri: Bağışıklık sisteminin enfeksiyonlara karşı verdiği yanıtları belirlemek için yapılan testler.
Mikrobiyoloji Laboratuvarının Teknolojik Altyapısı
Adana Güzelyalı Hastanesi, mikrobiyoloji bölümünde ileri teknolojiye sahip ekipmanlar kullanarak hızlı ve doğru sonuçlar elde eder:
- Otomatik Enfeksiyon Tanı Sistemleri: Numunelerin hızlı bir şekilde işlenmesi ve doğru sonuçların elde edilmesi için gelişmiş otomatik sistemler.
- Biyolojik Güvenlik Kabinleri: Testlerin güvenli bir şekilde yapılabilmesi için biyolojik güvenlik standartlarına uygun ortamlar.
- Mikroskopik İnceleme Sistemleri: Yüksek çözünürlüklü mikroskoplar ve dijital görüntüleme sistemleri kullanılarak mikroorganizmaların hızlı ve doğru şekilde incelenmesi.
Neden Adana Güzelyalı Hastanesi Mikrobiyoloji?
- Hızlı ve Güvenilir Sonuçlar: Mikrobiyoloji laboratuvarımızda kullanılan son teknoloji ekipmanlar sayesinde test sonuçları hızlı ve doğru bir şekilde elde edilir.
- Alanında Uzman Kadro: Mikrobiyoloji konusunda deneyimli uzman doktorlar ve laboratuvar teknisyenleri, hastalar için en iyi sonuçları elde etmek amacıyla çalışmaktadır.
- Kapsamlı Hizmet: Bakteriyel, viral, mantar ve paraziter enfeksiyonlar konusunda geniş bir test yelpazesi sunulmaktadır.
- Enfeksiyon Yönetimi: Mikrobiyoloji laboratuvarı, enfeksiyonların yönetimi ve önlenmesinde hastalara yardımcı olur, tedavi sürecini optimize eder.
Sonuç
Adana Güzelyalı Hastanesi Mikrobiyoloji bölümü, enfeksiyon hastalıklarının doğru bir şekilde teşhis edilmesi ve tedavi edilmesi için kritik bir rol oynamaktadır. Enfeksiyonlar konusunda kapsamlı testler ve analizler sağlayarak, hastaların hızlı bir şekilde iyileşmelerine katkıda bulunur. Mikrobiyoloji laboratuvarımız, hasta güvenliğini ön planda tutarak, en doğru ve hızlı sonuçları sunmaktadır.